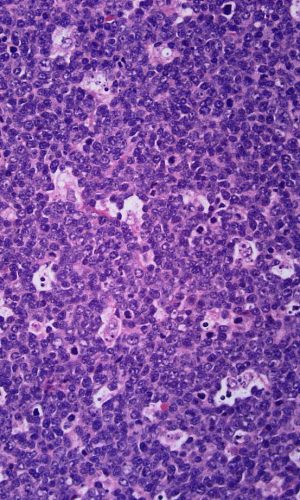

Hematopathology

DR. DENNIS HWANG
Hematopathology
Dr. Dennis Hwang is a board-certified hematopathologist and completed his hematopathology fellowship at UCSF. Contra Costa Pathology Associates offer specialized expertise in the diagnosis of various hematologic disorders including:
- Leukemias
- Lymphomas
- Myeloproliferative neoplasms
- Myelodysplastic syndromes
- Cytopenias
What to expect:
- Timely and accurate diagnoses.
- Thorough, informative reports that include results of flow cytometry, cytogenetics, molecular tests, immunohistochemical stains and other special studies, all incorporated into a comprehensive document with details critical to patient care.
- Enhanced clinicopathologic correlation and continuity of care for those patients receiving care at John Muir Medical Centers.
- Regular, ongoing interactions with oncologists, allowing clinical correlation and discussion of state of the art technologies, testing, and treatments.